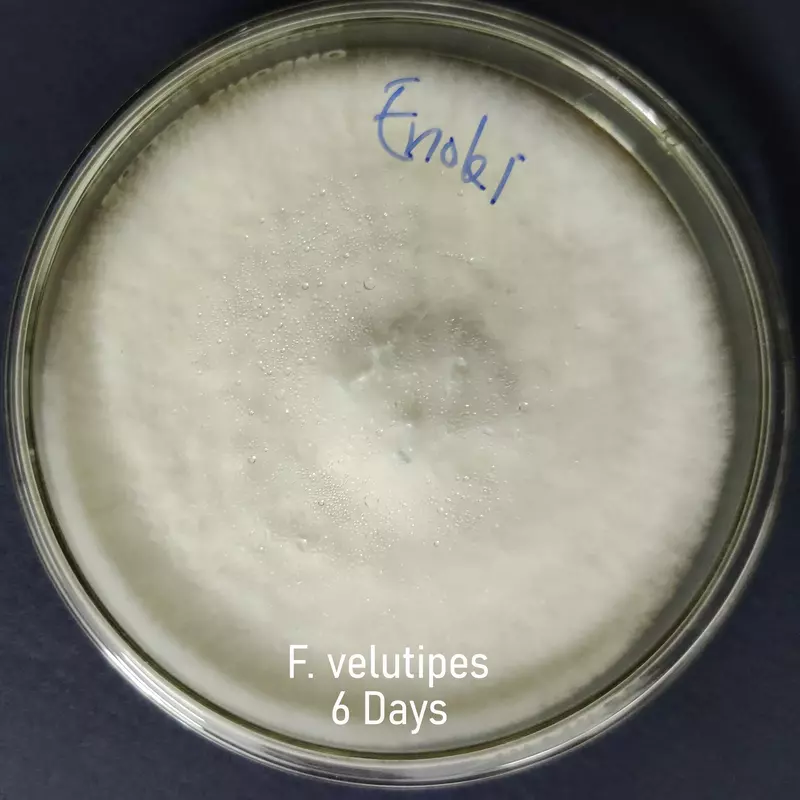

Flammulina velutipes (Enoki Mushroom) – Pure Culture Plate
Premium Flammulina velutipes (Enoki Mushroom) pure culture plate for gourmet and commercial mushroom cultivation. Known for its slender white stems, delicate caps, and mild umami flavor, this verified strain ensures consistent yields and vigorous mycelial growth under controlled conditions.
🍄 Proudly prepared and stored at Agripie Agrosystem LLP, India 🇮🇳
The Flammulina velutipes (Enoki Mushroom) – Pure Culture Plate offers a pure, contamination-free strain cultivated for reliable performance, high productivity, and uniform morphology.
Enoki mushrooms are a staple of East Asian cuisine, prized for their crisp texture, elegant appearance, and nutrient-rich composition.
This culture is ideal for commercial mushroom producers, training centers, and mycology labs, supporting both substrate inoculation and research applications. It performs best under low-temperature fruiting conditions (10–15°C), forming dense clusters of long, thin, snow-white mushrooms.
Features:
Verified pure Flammulina velutipes strain (Enoki Mushroom)
High yield and stable morphology under optimal fruiting conditions
Excellent for gourmet and commercial cultivation
Crisp, mild-flavored mushrooms with high nutritional value
Suitable for both research and spawn production applications
100% pure, lab-tested and contamination-free culture
🍄 Proudly prepared and stored at Agripie Agrosystem LLP, India 🇮🇳

 |
|  |
| 
